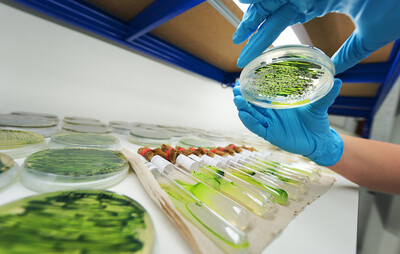
MENDELU has joined the space cluster, helping in the field of biotechnology

About us
Mendel University in Brno (MENDELU) is a public institution with a long tradition of excellence in teaching and research that has driven new ways of thinking since 1919 and proudly bears the name of Gregor Johann Mendel, the founder of modern genetics.
MENDELU offers more than 100 graduate degree programmes in the Czech and English languages. MENDELU comprises one university institute and five faculties. Modern university campus is located in Brno, the second-largest city in the Czech Republic, the heart of Europe. Brno is one of the best student cities in the world; in 2018 it was ranked among the Top 10 QS Best Student Cities rated by students.
Where to find us
Mendel University in Brno
Zemědělská 1665/1
613 00 Brno
Faculties
Faculty of Regional Development and International Studies
- International Territorial Studies
Faculty of Forestry and Wood Technology
- Forest Phytology
- European Forestry
- Wood Material Engineering
and next 5 programmes
Faculty of Business and Economics
- Economics and Management
- Open Informatics
- Applied Statistics and Operations Research
and next 2 programmes
Faculty of AgriSciences
- General Agriculture
- Applied Bioclimatology
- Molecular Physiology, Genetics and Biotechnology of Plants
and next 6 programmes
Admission and entrance exams
Admission requirements:
Each faculty at Mendel University has a different set of requirements and admits students through a separate application process. The requirements and admission fees vary from faculty to faculty depending on the chosen study programme. However, the general entry requirements for degree programmes are as follow:
complete on-line application form; provided certified copies of your original education certificates (especially those proving the highest level of education achieved – nostrified high school diploma); transcript of records/diploma supplement – provide us with a stamped printout of your study records; provide us with a scanned copy of your passport; motivation letter; supply any other relevant information or supporting documents that might higher your chances; entrance admission exam.
News
Additional information
There are approximately 10 thousand students at the university, and nearly 10 percent of them are international. MENDELU supports own international student club which runs the buddy system programme – Czech volunteer students help incoming students and partners with adaptation upon their arrival. The university also participates in many academic exchange programmes and organises special workshops, conferences, seminars and summer courses. Most of these activities are in English.
The university has its own dormitories and canteen.
The university consists of five faculties:
- FACULTY OF AGRISCIENCES
- FACULTY OF FORESTRY AND WOOD TECHNOLOGY
- FACULTY OF BUSINESS AND ECONOMICS
- FACULTY OF HORTICULTURE
- FACULTY OF REGIONAL DEVELOPMENT AND INTERNATIONAL STUDIES
Contact
Mendel University in Brno
Zemědělská 1665/1
613 00 Brno